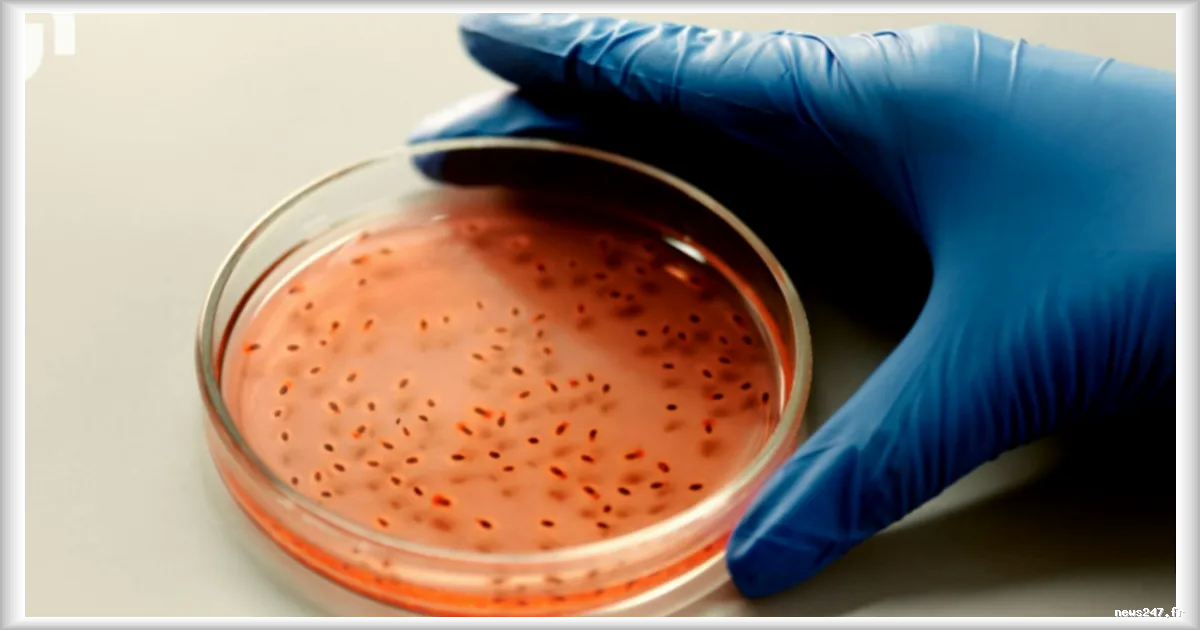
Bactéries miroir : de l'espoir scientifique à l'alerte mondiale de biosécurité

Le syndicat des journalistes tunisiens a exprimé ses inquiétudes concernant la propagation croissante des discours de haine et de racisme sur les réseaux sociaux, suite à un récent incident impliquant un député tunisien. Selon RFI, mi-avril, ce député a tenu des propos racistes vis-à-vis des femmes subsahariennes et du viol, suscitant une vive polémique. Ce cas n'est malheureusement pas un cas isolé, déplore le syndicat des journalistes.
Ce qu'il faut retenir
- Un député tunisien a tenu des propos racistes envers les femmes subsahariennes et le viol, déclenchant une polémique.
- Le syndicat des journalistes tunisiens alerte sur la multiplication des discours de haine et de racisme sur les réseaux sociaux.
Augmentation des discours de haine en ligne
Les professionnels de la presse ont publié un communiqué le lundi 20 avril dénonçant la montée alarmante des discours haineux et racistes qui se propagent de plus en plus sur les plateformes en ligne et finissent par contaminer l'espace médiatique. Cette tendance inquiétante soulève des questions sur l'impact de ces discours sur la société tunisienne et la nécessité de prendre des mesures pour contrer cette propagation.
La vigilance et la sensibilisation semblent être des éléments clés pour contrer cette tendance préoccupante.